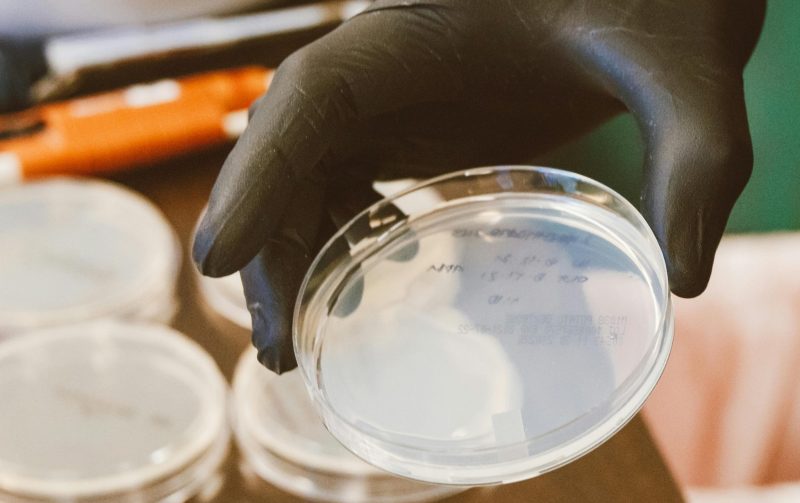
pexels-jess-vide-9259944

Precision-engineered specialty chemicals addressing industrial process challenges in India
Srivilas Hydrotech, founded in 1999, manufactures process-specific specialty chemicals—ranging from water treatment to coatings biocides—supported by ISO‑certified production, application testing, and localized technical service in India.

Srivilas operates ISO 9001:2008‑certified batch manufacturing facilities with an annual output exceeding 2,500 MT. Equipped with modern analytical and application labs, the company ensures consistent quality, tailored formulations, and technical support from site survey through implementation.
Srivilas’s portfolio spans:
01. When was Srivilas Hydrotech established?
02. What manufacturing capacity does Srivilas have?
03. Which industries does Srivilas serve?
04. What technical support is offered beyond supply?
Benefits and advantageswe offer to our customers
German Technology
Local Manufacturing
Global Support
Lab & Technical
At Onnovo, we go beyond supplying high-performance solutions—we partner with customers to enhance product quality, reduce costs, and improve efficiency.
Srivilas Hydrotech – Company Timeline
Commenced operations with a focus on industrial water treatment chemicals (boiler, cooling tower, and effluent systems).
Achieved production levels, reflecting 50% capacity growth and supported by market demand.
Expanded manufacturing by another 33% to match growing marketing. Enhanced technical service capabilities such as – Microbiology laboratory, site audits, custom formulation, and application-specific program design.
Post the JV with Onnovo Group, we have investment to increase production capacity by 200%; which will come in affect by early-2026.